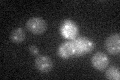
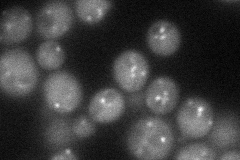
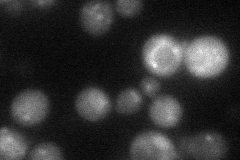
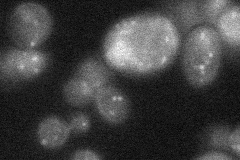

View description
Multivalent adaptor protein that facilitates vesicle-mediated vacuolar protein sorting by ensuring high-fidelity vesicle docking and fusion, which are essential for targeting of vesicles to the endosome; required for vacuole inheritance
Localization:
Intensity:
Fold change:
Significance:
-
C’ GFP library in SD
punctate16.86 -
N' NOP1pr-GFP in SD
punctate50.333 -
N' TEF2pr-mCherry in SD
punctate33.9577 -
N' NATIVEpr-GFP in SD
punctate25.6967 -
N' TEF2pr-VC and Cyto-VN in SD

below threshold28.7078 -
C’ GFP library in SD+DTT

punctate18.851.11No -
C’ GFP library in SD+H2O2

punctate19.611.16No -
C’ GFP library in Starvation Media

punctate21.221.25No -
C’ GFP library on the background of Pup2-DaMP

N/A -
C’ GFP library on the background of CCT mutant

N/A0N/AYes
